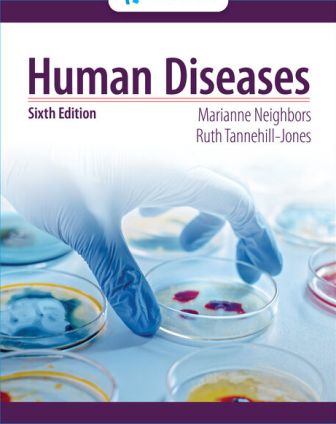

Solution Manual for Human Diseases 6th Edition Neighbors
Original price was: $100.00.$50.00Current price is: $50.00.
Solution Manual for Human Diseases 6th Edition By Marianne Neighbors, Ruth Tannehill-Jones, ISBN-10: 0357618041, ISBN-13: 9780357618042
Description
Human Diseases 6th Edition Neighbors
Solution Manual for Human Diseases 6th Edition By Marianne Neighbors, Ruth Tannehill-Jones, ISBN-10: 0357618041, ISBN-13: 9780357618042
Table of Contents
Part I: INTRODUCTION TO HUMAN DISEASES.
1. Introduction to Human Diseases.
2. Mechanisms of Disease.
3. Neoplasms.
4. Inflammation and Infection.
Part II: COMMON DISEASES AND DISORDERS OF BODY SYSTEMS.
5. Immune System Diseases and Disorders.
6. Musculoskeletal System Diseases and Disorders.
7. Blood and Blood-Forming Organ Diseases and Disorders.
8. Cardiovascular System Diseases and Disorders.
9. Respiratory System Diseases and Disorders.
10. Lymphatic System Diseases and Disorders.
11. Digestive System Diseases and Disorders.
12. Liver, Gallbladder and Pancreatic Diseases and Disorders.
13. Urinary System Diseases and Disorders.
14. Endocrine System Diseases and Disorders.
15. Nervous System Diseases and Disorders.
16. Eye and Ear Diseases and Disorders.
17. Reproductive System Diseases and Disorders.
18. Integumentary System Diseases and Disorders.
Part III: GENETIC/DEVELOPMENTAL, CHILDHOOD AND MENTAL HEALTH DISEASES AND DISORDERS.
19. Genetic and Developmental Diseases and Disorders.
20. Childhood Diseases and Disorders.
21. Mental Health Diseases and Disorders.